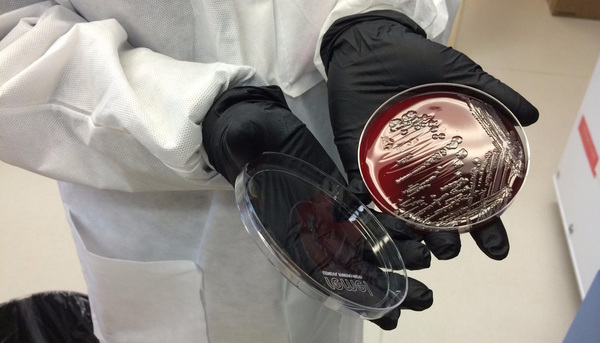

Suffering from a sore throat or runny nose? For some people, that many mean opting to use antibiotics without seeing a doctor, a practice that health experts say may not help cure the disease and could help aggravate the problem of antibiotic-resistant germs.
A study published Monday in the journal Antimicrobial Agents and Chemotherapy concluded that many people are tempted to use antibiotics without a doctor's prescription. They rely on drugs purchased from ethnic grocery or drug stories or the leftovers in their medicine cabinets, potentially contributing to the spread of antibiotic-resistant bacteria and causing damaging side effects.
"This kind of inappropriate use is very risky," said Larissa Grigoryan, co-author of the study and an instructor at the Baylor College of Medicine in Houston. "If you use antibiotics irresponsibly like this then resistance rates will increase."
Between April and August last year, researchers surveyed 400 people in the waiting rooms of three primary care clinics around Houston, asking about their use of antibiotics in the past year. Two were public family medicine clinics serving diverse, mostly uninsured or underinsured patients. The third clinic served primarily managed care and privately insured patients. The survey participants were selected randomly to represent the racial and socioeconomic makeup of Harris County, one of the most populous counties in the state.
Researchers found that 5 percent of patients surveyed reported using antibiotics without prescriptions during the previous 12 months. However, 25 percent of the respondents said they were willing to use antibiotics if possible without contacting a medical professional. Fourteen percent stored antibiotics at home, most of which were left over from previous prescriptions. Those who stored antibiotics were 4.2 times more likely to indicate that they would use antibiotics without prescriptions.
The most common types included amoxicillin, azithromycin, ciprofloxacin and penicillin.
"The part that was most alarming is the percentage of people who say they would use antibiotics without contacting their doctors," Grigoryan said.
Of the 5 percent who used nonprescription antibiotics, 40 percent of them purchased the drugs from pharmacies, even though such sales are illegal. Earlier studies have found that ethnic drug stores and groceries often sell antibiotics without prescriptions. Nearly a quarter of these people said they got the drugs from another country.
The patients also reported they got these medicines from relatives or friends.
Overuse and misuse of antibiotics is a concern because resistance to the drugs is a global threat, rendering procedures such as routine surgeries vulnerable to fatal infections.
According to the Centers for Disease Control and Prevention, antibiotic resistance causes more than 23,000 deaths per year in the United States with more than 2 million Americans infected with antibiotic-resistant pathogens.
Antibiotic resistance occurs when bacteria adapt to the drugs, rendering the antibiotics useless against fighting infections. That sometimes happens when consumers misuse antibiotics, such as not taking a full course of the drug regimen prescribed by a physician.
The use of nonprescription antibiotics was more likely among those who use public clinics. Grigoryan speculates that those patients might do so to save money. "One of the reasons might be the co-pay ... they still have to pay to see a doctor," Grigoryan said, adding that another reason could involve getting to a medical appointment. "They don't have adequate transportation."
According to the study, most patients wanted the antibiotics to treat respiratory symptoms, such as a cough, sore throat or sinus infection. Previous research has shown that such symptoms, though the most common reason for antibiotic prescription among adults, are often viral rather than bacterial. Antibiotics are not effective for viral infections such as a cold. Still, physicians have been known to prescribe antibiotics unnecessarily when pressured by patients.
Researchers said a solution is to rein in illegal over-the-counter antibiotic sales in pharmacies or local stores. But Grigoryan said the main strategy should be education. The CDC and its European counterpart have launched campaigns to raise public awareness.
"We really need to educate the public it is risky to take antibiotics without contacting a doctor," Grigoryan said. "You don't need antibiotics for a minor illness."







